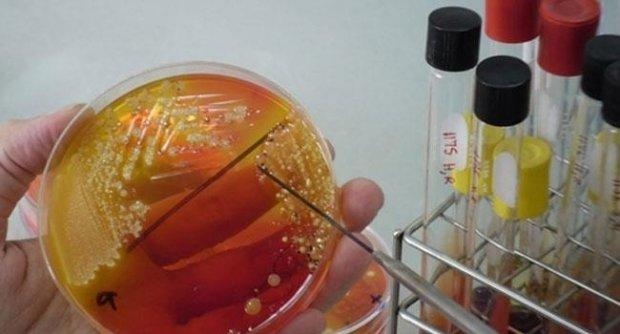
8

ดร.ชุติมา เอี่ยมโชติชวลิต ผู้ว่าการ สถาบันวิจัยวิทยาศาสตร์และเทคโนโลยีแห่งประเทศไทย (วว.) กระทรวงการอุดมศึกษา วิทยาศาสตร์ วิจัยและนวัตกรรม (อว.) พร้อมด้วย ดร.ฉัตรฤดี สุวรรณชาติ นักวิจัยอาวุโส และ ดร.สุสกุล ปาลกะวงศ์ ณ อยุธยา นักวิจัยอาวุโส ศูนย์ความหลากหลายทางชีวภาพ (ศคช.) วว. ร่วมหารือกับ Dr. Kim Cha Young และ Dr. Kim Song Gun สถาบัน Korean Collection for Type Culture (KCTC) ซึ่งเป็นหน่วยงานที่รับฝากจุลชีพระหว่างประเทศ ในวันที่ 10 พฤษภาคม 2566 ณ เมือง Jeung-eup ประเทศสาธารณรัฐเกาหลี ในประเด็นการเก็บรักษาเชื้อจุลินทรีย์และงานวิจัยที่เกี่ยวข้องกับจุลินทรีย์ เพื่อต่อยอดการใช้ประโยชน์จากทรัพยากรชีวภาพโดยเฉพาะจุลินทรีย์ที่เก็บรักษา ณ ศูนย์จุลินทรีย์ วว. ซึ่งเป็นแหล่งกลางรวบรวมเก็บรักษาสายพันธุ์จุลินทรีย์นอกถิ่นกำเนิด ที่มีประโยชน์ในการเกษตร อุตสาหกรรม สิ่งแวดล้อม ภายใต้มาตรฐาน ISO 9001 : 2008, ISO 9001 : 2015 , ISO/IEC 17025


และยังเป็นหน่วยบริการด้านจุลินทรีย์ (service culture collection) แห่งเดียวในประเทศไทย ที่ได้รับการจัดตั้งขึ้นโดย UNESCO เมื่อปี พ.ศ. 2519 ให้ทำหน้าที่เป็นศูนย์ในระดับภาคพื้นเอเชียอาคเนย์และเป็นศูนย์เครือข่ายระดับโลก (UNESCO World Network of Microbiological Resources Centre-MIRCEN ) ดำเนินกิจกรรมงานวิจัย งานบริการด้านจุลินทรีย์ เพื่อการอนุรักษ์และการใช้ประโยชน์ทรัพยากรจุลินทรีย์อย่างยั่งยืน ปัจจุบันมีสายพันธุ์จุลินทรีย์ ได้แก่ แบคทีเรีย ยีสต์ รา และแอคติโนมัยสีท (จุลินทรีย์ที่สามารถสร้างสารออกฤทธิ์ทางชีวภาพ) เก็บรวบรวมไว้ในศูนย์มากกว่า 11,000 สายพันธุ์ โดยในแต่ละปีให้บริการสายพันธุ์จุลินทรีย์แก่กลุ่มลูกค้า อาทิ สถาบันการศึกษา หน่วยงานภาครัฐและเอกชน มากกว่า 1,000 สายพันธุ์

ศูนย์จุลินทรีย์ วว. ให้บริการ ดังนี้
1) บริการสายพันธุ์จุลินทรีย์ ได้แก่ แบคทีเรีย ยีสต์ รา และแอคติโนมัยสีท
2) บริการเก็บรักษาสายพันธุ์จุลินทรีย์ เพื่อฝากเก็บแบบเผยแพร่แก่สาธารณะ ฝากเก็บแบบไม่เผยแพร่ และการยื่นขอจดสิทธิบัตร
3) บริการจัดจำแนกสายพันธุ์จุลินทรีย์ด้านชีวเคมีและชีวโมเลกุล ได้แก่ แบคทีเรีย ยีสต์ รา และแอคติโนมัยสีท
4) บริการศึกษาความหลากหลายทางชีวภาพในตัวอย่างด้วยเทคโนโลยีลำดับเบสที่พัฒนาขึ้นใหม่
5) บริการวิเคราะห์และทดสอบด้านจุลชีววิทยา ได้แก่ การตรวจนับจำนวนจุลินทรีย์ การทดสอบสารออกฤทธิ์ทางชีวภาพ
6) บริการวิเคราะห์ทดสอบความคงตัวด้านจุลชีววิทยาของผลิตภัณฑ์
7) บริการวิจัย
8) บริการฝึกอบรมบุคลากรด้านการเก็บรักษาจุลินทรีย์และการจัดจำแนกจุลินทรีย์
9) บริการถ่ายภาพจุลินทรีย์
สอบถามรายละเอียดและรับบริการจาก วว. ติดต่อได้ที่ โทร. 0 2577 9000 , โทรสาร 0 2577 9009 หรือที่ “วว. JUMP” https://tistrservices.tistr.or.th/
![]()
กระทรวงการอุดมศึกษา วิทยาศาสตร์ วิจัยและนวัตกรรม (อว.)
เป็นหน่วยงานของรัฐที่จัดตั้งขึ้นเพื่อขับเคลื่อนการอุดมศึกษาไทย วิทยาศาสตร์ วิจัยและนวัตกรรม ไปสู่มาตรฐานในระดับสากล และเพิ่มอันดับความสามารถการแข่งขันในระดับนานาชาติอย่างยั่งยืน ไม่ได้มีวัตถุประสงค์เพื่อแสวงหากำไร หากท่านพบว่ามีข้อมูลใดๆ ที่ละเมิดทรัพย์สินทางปัญญาปรากฏอยู่ในเว็บไซต์นี้ โปรดแจ้งให้ทราบ เพื่อดำเนินการแก้ปัญหาดังกล่าวโดยเร็วที่สุดต่อไป
© 2020 Ministry of Higher Education, Science, Research and Innovation. ALL RIGHTS RESERVED.